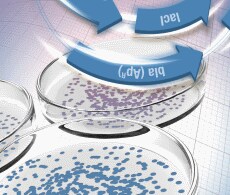
sho-cloning-kits sho-cloning-kits

Search
Search
分子克隆是分子生物学工作流程的关键组成部分,其可用于组装重组 DNA 分子并指导其复制。在分子克隆工作流程中,待克隆的 DNA 经过鉴定,并用酶对其进行处理以产生 DNA 片段。然后将这些片段与载体 DNA 组合以产生重组 DNA 分子。
了解更多有关用于高效分子克隆的 PCR 克隆试剂盒、细菌表达和连接酶-克隆试剂盒、酶和 DNA 载体。
用于 DNA 末端修饰的酶,例如 T4 DNA 连接酶、碱性磷酸酶、PNK、Klenow 片段、以及 T4 DNA 聚合酶。
用于蓝/白菌落选择的 IPTG 和 X-gal。
用作分子克隆载体的 pUC 质粒和 λDNA。
宽范围的DNA Ladders,可用于对琼脂糖凝胶或聚丙烯酰胺凝胶中的DNA进行精确的片段大小区分及定量。
用于DNA扩增反应的高纯度核苷酸。
用于高效cDNA合成的反转录酶、引物、核苷酸及试剂盒。
Phusion高保真DNA聚合酶、试剂盒及聚合酶。
该“如何”系列视频展示了,作为克隆工作流程的一部分,如何使用赛默飞世尔科技快速 DNA 连接试剂盒实现快速有效的连接。
仅供科研使用,不可用于诊断目的。